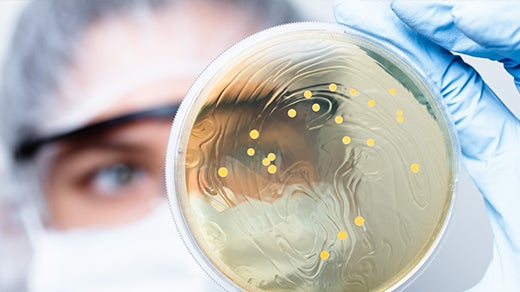

ペブルコーポレーション株式会社のプレスリリース
ペブルコーポレーション株式会社(本社:東京都江東区、代表取締役:藤方 裕伸、以下ペブルコーポレーション)が予約販売を行っておりますNMN配合の国産青汁『美健NMN青汁』(ビケンNMNアオジル)について、予約開始直後から多くのお問合せをいただき、瞬く間に予約枠が埋まってしまいましたが、この度、工場の生産体制が整ったことにより追加で150個のみ増産することが可能となりましたので予約販売を再開いたします。

- 予想をはるかに超えるお問合せをいただいた『美健NMN青汁』
健康志向の高まる昨今において、若々しさと健康を維持するための重要な栄養素として注目が高まっているNMN(ニコチンアミドモノヌクレオチド)を国産青汁に高配合。さらにエイジングケアに適した乳酸菌H61株も配合した『美健NMN青汁』は4月末の予約販売開始直後から美容と健康に感度の高い方々をはじめ、多くのご予約やお問合せをいただいておりました。
限定生産のため仕入れ数に限りがありましたが、多くのお問合せに答えるべく工場側とも相談を重ね、わずかながら増産体制が整いましたので、追加150個の予約販売を再開いたします。
※数に限りがございますので早めのご予約をオススメいたします。
- こだわり① NMNの特徴

NMN(ニコチンアミドモノヌクレオチド)とは枝豆や母乳に含まれる成分のひとつで、体内で自然に作られている物質です。
全ての生命体のエネルギー源であり、人間の活動を支えるエネルギーを生産するために必要なNADという酵素に変換される成分ですが、加齢とともに減少していくことが研究で分かっております。NADそのものは体に吸収されないため、NADに変換される前駆体のNMNを摂取することが大切で、歳を重ねてもなお、美しさを保ち(エイジングケア(※1))イキイキとした活動を支える(ウェルネス)成分として期待されております。
※1 年齢に応じた栄養面のケア
『美健NMN青汁』のNMNは量産に適した化学合成法ではなく、酵母発酵法で作られた純度100%(※2)かつ無香料、無着色の生NMNを原料(国内製造)として使用しており、徹底的に品質試験を行っております。
※2 規格値は99%以上、外部機関による分析結果は純度100%(Lot.2021.04)
- こだわり② 青汁の特徴

一般的な青汁は、若葉を熱乾燥させて粉末にする製法で作られておりますが、『美健NMN青汁』の青汁はフレッシュな大麦若葉を高圧力で絞り、葉の不順繊維を除くコールドプレス製法で作られた【生搾り大麦若葉エキス末】の青汁を使用しております。
熱乾燥の製法に比べて素材本来のおいしさを引き出すことができ、添加物を使わずナチュラルな味わいに仕上げております。
- こだわり③ 乳酸菌H61株の特徴
乳酸菌H61株は国立研究開発法人 農業・食品産業技術総合研究機構(農研機構)が発見・分離した乳酸菌で農研機構が保有する3000種類を超える乳酸菌の中でエイジングケアに適した乳酸菌として選定されました。
美しさとうるおいに満ちた毎日をサポートする乳酸菌であることがわかりました。
『美健NMN青汁』はエイジングケアができ、うるおいとハリをもらす乳酸菌もNMN・青汁と合わせて摂取できる贅沢な製品となっております。
▼詳しくは公式サイトへ
https://ao-jiru.com
【こんな悩みがある方におすすめ】
- 綺麗に年を重ねていきたい
- しっかりと寝ているのに起きると体が重い
- メイクやファッションが気になる
- ハリやうるおいに不安を感じている
- エイジングケアを頑張ってもなかなか実感できない
- まだまだ元気でいたい!
- 商品詳細

<商品名>
美健NMN青汁(ビケンNMNアオジル)
<内容量>
1箱 30包入り
<販売価格>
1箱 7,950円/税込(送料別途)
<主要成分>
・ニコチンアミドモノヌクレオチド(NMN)(配合量9000mg/30包)
・大麦若葉エキス末(大麦若葉(北海道)、難消化性デキストリン、デキストリン)
・乳酸菌H61(澱粉分解物、殺菌乳酸菌)
<生産国>
日本
<予約ページ>
https://ao-jiru.com
※本製品は予約販売となっております。商品の発送は5月下旬を予定しております。
※初回は都度販売のみとなります。定期購入については今後実施を予定しております。
※ご購入はお一人様1点のみとさせていただきます。
ペブルコーポレーション株式会社について
事業概要: ECの立ち上げから集客・物流までのワンストップ運用サービス『GPX-N』、IT技術を活用した各種検査キットの取り扱い、AIとDX、既存テクノロジーの融合による高付加価値技術、およびIoT・5G製品の開発
設立: 2018年12月7日
所在地:東京都江東区有明3-6-11 TFTビル 8階 Aバンク
代表者:代表取締役社長 藤方 裕伸
URL:https://pebblecorp.co.jp/

